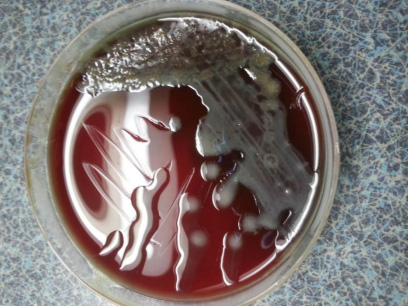

一、什么是铜绿假单胞菌呢?
铜绿假单胞菌(P.aeruginosa)是假单胞菌属的代表菌种,1882年法国微生物学家Carle Gessard首次从士兵伤口感染中分离到,因其脓液呈绿色——在生长过程中能产生水溶性色素绿脓素,故在江湖上又被称为绿脓杆菌,为条件致病菌,是医院内感染最常见病原菌之一。

二、铜绿假单胞菌有哪些生物学特性呢?
铜绿假单胞菌本身是一种革兰氏阴性杆菌,呈球杆状或长丝状,菌体大小(0.5-1.0)um ×(1.5-5.0)um,长短不一,单个、呈双或短链状排列。无芽孢,有荚膜,菌体一端有单鞭毛,运动很活泼,临床分离株常有菌毛。
铜绿假单胞菌虽为专性需氧菌,但部分菌株可以利用硝酸盐作为替代的电子受体,使它在厌氧环境下也能生长。营养要求不高,可生长的温度范围为25-42℃,最适生长温度为35℃,4℃不生长而42℃生长是它的一个特点。
铜绿假单胞菌在普通琼脂培养基上有典型的生姜气味,可产生多种色素,主要为绿脓素和荧光素,从临床标本中分离的菌株约有80%-90%可产生绿脓素和荧光素。

在血琼脂培养基上可形成不同形态的菌落,典型菌落为灰绿色,大小不一,扁平湿润,边缘不规则,呈伞状伸展,表面常可见金属光泽,这种光泽通常与菌落的自溶有关。它还可以出现其他菌落形态,比如光滑、黏液性和侏儒菌落(又叫小菌落变异型),其中黏液性菌落变异型在囊性纤维化患者的呼吸道标本中特别常见。
三、铜绿假单胞菌在细菌界拥有啥子江湖地位呢?
CHINET中国细菌耐药监测结果(2022年1-12月)显示,铜绿假单胞菌在主要临床分离菌种分布中排第四。

究其根源,一方面铜绿假单胞菌广泛分布在自然界、人的体表、胃肠道、呼吸道、泌尿生殖道等处;而且特别容易在伤口和黏膜表面、重症监护和使用广谱抗生素治疗的患者口咽部以及接受机械通气患者的气管插管或气道中定植。
另一方面,一旦患者伴有中性粒细胞减少、糖尿病、皮肤烧伤、囊性纤维化和 HIV / AIDS等感染高风险因素后,就极易引起继发性感染,且引起的感染通常与医疗操作有关。
应特别注意这些风险较高的患者:急性白血病诱导化疗或骨髓移植的受体/供体、接受气管插管或气管切开等机械通气操作的患者、烧伤创面感染(多在烧伤一周后出现)和慢性伤口感染患者等。
此外,肺功能测定、雾化或清洁气道时的气溶胶传播也是引起铜绿假单胞菌医院感染的因素。
四、哪铜绿假单胞菌的耐药性又咋样呢?
铜绿假单胞菌不仅本身对很多抗生素天然耐药,而且它的获得性耐药能力还很强。其获得性耐药机制主要包括染色体位点突变或从其他耐药菌获得质粒、转座子、整合子所携带的耐药基因。耐药表现包括高产 AmpC 酶、 OprD 孔蛋白缺失、氟喹诺酮类抗生素高水平耐药等。临床分离株中铜绿假单胞菌多重耐药的情况比较严重,都是因为这个耐药性通常都是由多种耐药机制共同发挥作用。
铜绿假单胞菌耐药性还有另外一个重要的特点叫适应性耐药,换句话说就是在环境诱导物存在的情况下才会表现出来的耐药。目前晓得的诱导因素包括抗生素、氧化应激、厌氧环境、阳离子和碳源,这些因素可调控多种基因表达,造成适应性耐药。有时这种适应性耐药并不需要遗传物质的改变,而只是通过细菌调控网络发挥耐药的功能。一旦诱导因素消失后,如抗生素暴露停止、调控网络被关闭,菌株就恢复敏感。
所以你说它拽不拽?
五、怎么预防医院感染和治疗呢?
将感染患者隔离、使用一次性器具、医护人员及探访者及时规范手卫生、床单元终末消毒等感染控制措施可帮助阻止医院感染的发生。
铜绿假单胞菌感染治疗较为棘手,药敏结果可作为用药指导。对体外敏感的药物,单药治疗足够。肺部感染患者不建议采用多尼培南治疗,非中性粒细胞减少患者不建议两种药物联合治疗。铜绿假单胞菌在治疗过程中易发生非黏液型向黏液型转变和适应性耐药,故在抗生素使用过程中,建议增加培养送检频率,对铜绿假单胞菌药敏变化进行监测。
作者:自贡市第三人民医院 颜小平
医院地址:四川省自贡市贡井区筱溪街胜利巷156号
急救电话:0813-3301234
人事科:0813-3302254 健康管理中心:0813-3301250
咨询电话:0813-3319575
投诉电话:0813—3303897、0813-3313732(白天 )
0813—3301040(中夜班及节假日)
邮箱:office@zgsyy.cn 邮编:643020
医院周边公共交通情况:万年灯:16路、贡井人寿保险门口:15路、11路、17路
公开院外周边停车场位置及配套服务设施:医院西区停车场、虎头桥国投停车场、恒太城停车场
扫一扫关注官方微信
Copyright © 2006-2026 自贡市第三人民医院版权所有 备案号:蜀ICP备13027823号-1 技术支持:四川百信智创科技有限公司